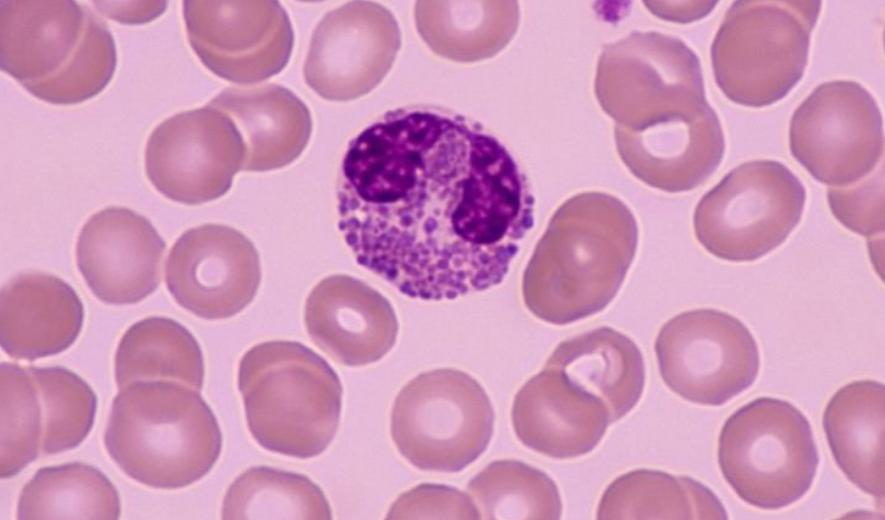

BS.CK1 Lâm Thiên Huệ - Khoa Hồi sức tích cực, Bệnh viện Gia An 115
U hạt bạch cầu ái toan lành tính có phải mổ?
Câu hỏi
Chào bác sĩ.
2 hôm trước em đi chụp MRI sọ não. Kết quả em bị tổn thương hủy xương sọ trán phải đường kính 18mm. Là u hạt bạch cầu ái toan lành tính. Bác sĩ nói chưa cần mổ. Cho em hỏi khi nào thì em phải mổ, u có tự mất đi không ạ? Em cám ơn.
Trả lời
Chào bạn,
Theo nguyên tắc chung một khối u cần phải phẫu thuật nếu khối u đó là một khối u ác tính hoặc bắt đầu có hiện tượng chèn ép các cơ quan xung quanh, hoặc lan vào các mô cơ quan xung quanh gây mất chức năng.
Nếu đã khẳng định khối u hủy xương trong vùng trán là lành tính và không nguy hiểm, không ảnh hưởng vào tế bào nhu mô não thì không cần tiến hành phẫu thuật nhé bạn.
Thân ái chào bạn.
Bài viết có hữu ích với bạn?
Được tìm nhiều:
Có thể bạn quan tâm
Đăng ký nhận bản tin sức khoẻ
Để chủ động bảo vệ bản thân và gia đình
Đăng ký nhận bản tin sức khoẻ để chủ động bảo vệ bản thân và gia đình






























